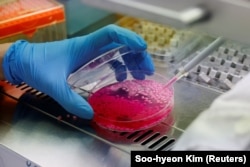
นักวิจัยปลูกถ่ายเซลล์เนื้อวัวเข้าไปในเมล็ดข้าว ให้ได้ "ข้าวเนื้อวัว"

นักวิจัยในเกาหลีใต้ประสบความสำเร็จในการปลูกถ่ายเซลล์เนื้อเยื่อของวัวในเมล็ดข้าวจนออกมาเป็นผลผลิตใหม่ที่ถูกชี้ว่าเป็นก้าวย่างสำคัญของการค้นหาแหล่งสารอาหารโปรตีนที่เป็นมิตรกับสิ่งแวดล้อม ในราคาที่ไม่สูงและยั่งยืนที่อาจมาทดแทนการทำฟาร์มเลี้ยงวัวเพื่อเชือดและนำเนื้อมาบริโภค ตามรายงานของสำนักข่าวเอพี
ศาสตราจารย์ จินคี ฮง จากมหาวิทยาลัยยนเซ (Yonsei University) ในกรุงโซล ซึ่งเป็นผู้นำทีมงานวิจัยที่ตีพิมพ์ในวารสาร Matter ฉบับเดือนนี้ กล่าวว่า “ข้าวเนื้อวัว” นั้นเป็นผลิตภัณฑ์ดั้งเดิมที่ไม่เคยมีใครคิดค้นขึ้นมาก่อน โดยใช้อนุภาคของเมล็ดข้าวมาเป็นฐานสำหรับการเพาะเซลล์กล้ามเนื้อและไขมันสัตว์
ในงานทดลองนี้ นักวิจัยเติมเอนไซม์เข้าไปในเมล็ดข้าวเพื่อช่วยให้เซลล์เจริญเติบโตได้ดี ก่อนจะฉีดเซลล์ของวัวที่เพาะขึ้นมาเข้าไปเพื่อให้ได้ผลผลิตลูกผสมซึ่งมีลักษณะเหมือนเมล็ดข้าวสีชมพู
ทีมงานของมหาวิทยาลัยยนเซไม่ได้เป็นเป็นทีมแรกที่ทดลองพัฒนาผลิตภัณฑ์เนื้อสัตว์ที่เพาะขึ้นในห้องปฏิบัติการทางวิทยาศาสตร์ เพราะบริษัทหลายแห่งทั่วโลกได้เปิดตัวโครงการผลิตเนื้อสัตว์ด้วยการเพาะเซลล์ไปแล้ว เช่น เนื้อไก่ที่เพาะจากเซลล์พืชและเนื้อปลาไหลที่เพาะจากถั่วเหลืองที่มีจำหน่ายในสิงคโปร์
สำหรับงานวิจัยของศาสตร์จารย์ฮงนั้น ทีมงานกล่าวว่า ข้าวที่เพาะขึ้นมีได้มีความได้เปรียบในแง่ของความปลอดภัย เมื่อเทียบกับถั่วเหลืองหรือถั่ว เพราะเป็นสิ่งที่มีคนน้อยมากมีอาการแพ้
รายงานข่าวระบุว่า “ข้าวเนื้อวัว” นี้มีโปรตีนมากกว่าข้าวปกติราว 8% และมีไขมันมากกว่าประมาณ 7% โดยศาสตราจารย์ฮง กล่าวว่า โปรตีนนี้มีสัดส่วน 18% ที่มาจากเนื้อสัตว์ ทำให้ผลผลิตนี้อุดมไปด้วยกรดอะมิโนที่มีประโยชน์อยู่มาก
ในส่วนของราคานั้น ศาสตราจารย์ฮงประเมินว่า อยู่ที่ราว 2 ดอลลาร์ต่อกิโลกรัม ขณะที่ ปริมาณก๊าซเรือนกระจกที่ถูกปล่อยออกมาจากกระบวนการผลิตนั้นต่ำกว่าการผลิตเนื้อวัวแบบปกติอย่างมากด้วย
อย่างไรก็ดี ผลิตภัณฑ์นี้ยังเผชิญกับความท้าทายหลายอย่าง ตั้งแต่เรื่องของอุปสรรคด้านเทคนิคไปจนถึงการที่จะต้องเอาชนะใจผู้บริโภคในด้านรสชาติและเนื้อสัมผัส
- ที่มา: รอยเตอร์

กระดานความเห็น